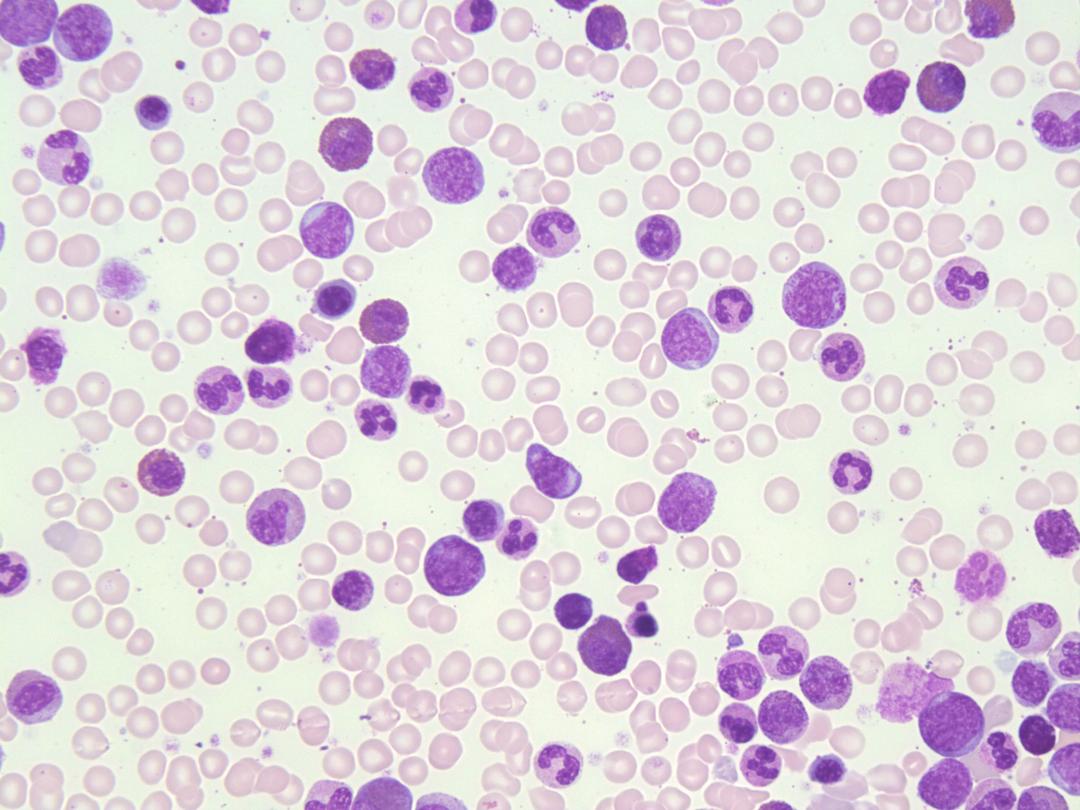
Chronic Myeloid Leukaemia
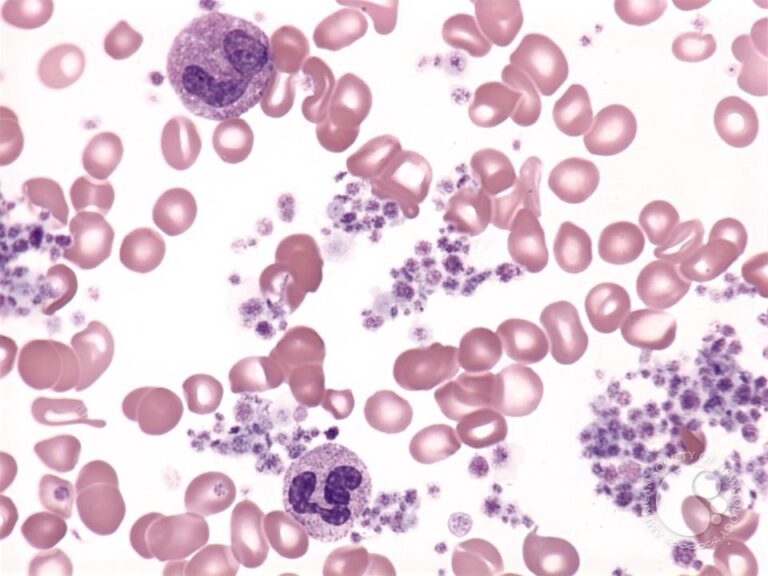
Myeloproliferative Neoplasms

Our Support & Programs
HELP US SERVE HUMANITY
When you choose to fundraise, donate or volunteer, you have the power to make a real difference for the blood cancer community. With you on our side, cancer doesn’t stand a chance!
Donate
THE BIRTH OF THE BLOOD CANCER FOUNDATION
The Advanced Oncology Podcast with the founder of the Blood Cancer Foundation Ghana, Dr. Emmanuel Antiri Kissiedu.

Advocating for the Blood Cancer Community
The Blood Cancer Foundation Ghana (BCFG) advocates for equitable and timely access to treatment and cancer care throughout Ghana. As blood cancer treatments advance, it is crucial to prepare our healthcare system and drug payors to help make these treatments available promptly. BCFG is committed to engaging with key stakeholders within the healthcare system and in each region to ensure that the needs of the blood cancer community are being met. To amplify the voice of the blood cancer community, BCFG is partnering with organisations in Ghana and other countries, with common goals to extend the impact of our advocacy efforts. If you have an immediate concern about access to treatment and care for you or a loved one, reach out to us.
Success Stories
By Ghanaians affected by Blood Cancer

Princilla
Age: 20 years
Location: Western Region
When I first heard the words, “You have small non-Hodgkin lymphoma,” on 9th December 2023, it felt like my world had been turned upside down.

Diana Amoah
Age: 20 years
Location: Western Region
In 2018, at 20, I began experiencing what I initially believed to be a routine toothache. However, the pain progressed into noticeable swelling in my lower jaw.

Ahmed Quansah
Age: 52 years
Location: Western Region
I was diagnosed with the commonest type of non-Hodgkin lymphoma called diffuse large B-cell lymphoma in 2022.
Seth
Age: 21 years
Location: Eastern Region
Diagnosed with T-Cell Lymphoma at age 21, Seth’s journey from illness to remission is one of courage, faith, and resilience.

Hassane Dari
Age: 54 years
Location: Western Region
I was diagnosed with multilineage Myelodysplastic Syndrome (MDS), a condition that affected both my red blood cells and my platelets.
Common Types of Blood Cancers
According to the WHO, blood cancers include acute and chronic leukaemias, myeloproliferative neoplasms, myelodysplastic syndromes, plasma cell dyscrasias, lymphomas, and histiocytic neoplasms.

Acute Myeloid Leukaemia (AML)
Rapidly progressing cancer of myeloid cells requiring urgent treatment.
Learn more
Acute Lymphoblastic Leukaemia (ALL)
Fast-growing leukaemia of lymphoid precursors, common in children.
Learn more
Chronic Lymphocytic Leukaemia (CLL)
Often slow-growing; some patients are monitored before treatment.
Learn more
Chronic Myeloid Leukaemia (CML)
Linked to the Philadelphia chromosome; highly treatable with targeted therapy.
Learn more
Myelodysplastic Syndromes
Ineffective blood cell production with risk of progression to AML.
Learn more
Plasma Cell Dyscrasias
Disorders involving abnormal plasma cells, including multiple myeloma.
Learn more

Stay Informed
Reliable information and real stories of hope can empower anyone living with a blood cancer. Join our mailing list for updates, resources, and events.
Get news, events, and patient stories from the Blood Cancer Foundation Ghana.


